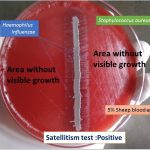
Satellitism test for the identification of Haemophilus influenzae
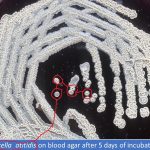
Turicella on blood agar showing donut colony

Collection Group: Clinical Bacteriology
Satellitism Test for the Identification of Haemophilus influenzae: Introduction, Principle, Procedure and Result Interpretation
Satellitism Test for the Identification of Haemophilus influenzae Satellitism test...
Satellitism Test for the Identification of Haemophilus influenzae Satellitism test...
Haemophilus influenzae on Chocolate Agar and Its Details
 Haemophilus influenzae on Chocolate Agar Haemophilus influenzae colonies on chocolate agar...
Haemophilus influenzae on Chocolate Agar Haemophilus influenzae colonies on chocolate agar...
Turicella on Blood Agar Showing Donut Colony and Its Details
Turicella on Blood Agar Showing Donut Colony Turicella otitidis on...
Turicella on Blood Agar Showing Donut Colony Turicella otitidis on...
